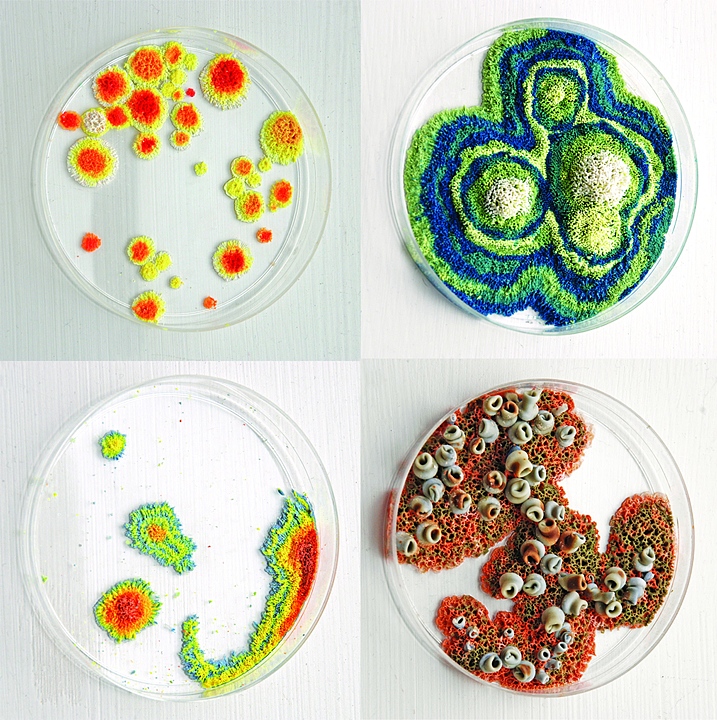

Как сделать петри
Как сделать петри 114 фото
Сколько жарится куриные кусочки
Национальный парк новой зеландии
Матч франция евро
Куриные желудочки по корейски рецепт
Игры люди кс
Подключение домофона с электромагнитным замком на калитку
Masha va ayiq uzbek tilida yangi
Дивизия нормандия
Поставь открываю картинки
Natural wonder the great barrier
Гоголь мертвые души ноздрев описание
Honor 90 год выпуска
Брэд питт с тортом
Песня канала а4
Увидеть пароль в браузере
Можно ли перекачивать воду
Поручения в младшей группе картотека с целями
Откуда приходят зачисления
Azur air багаж кг
Драйвер звука 8